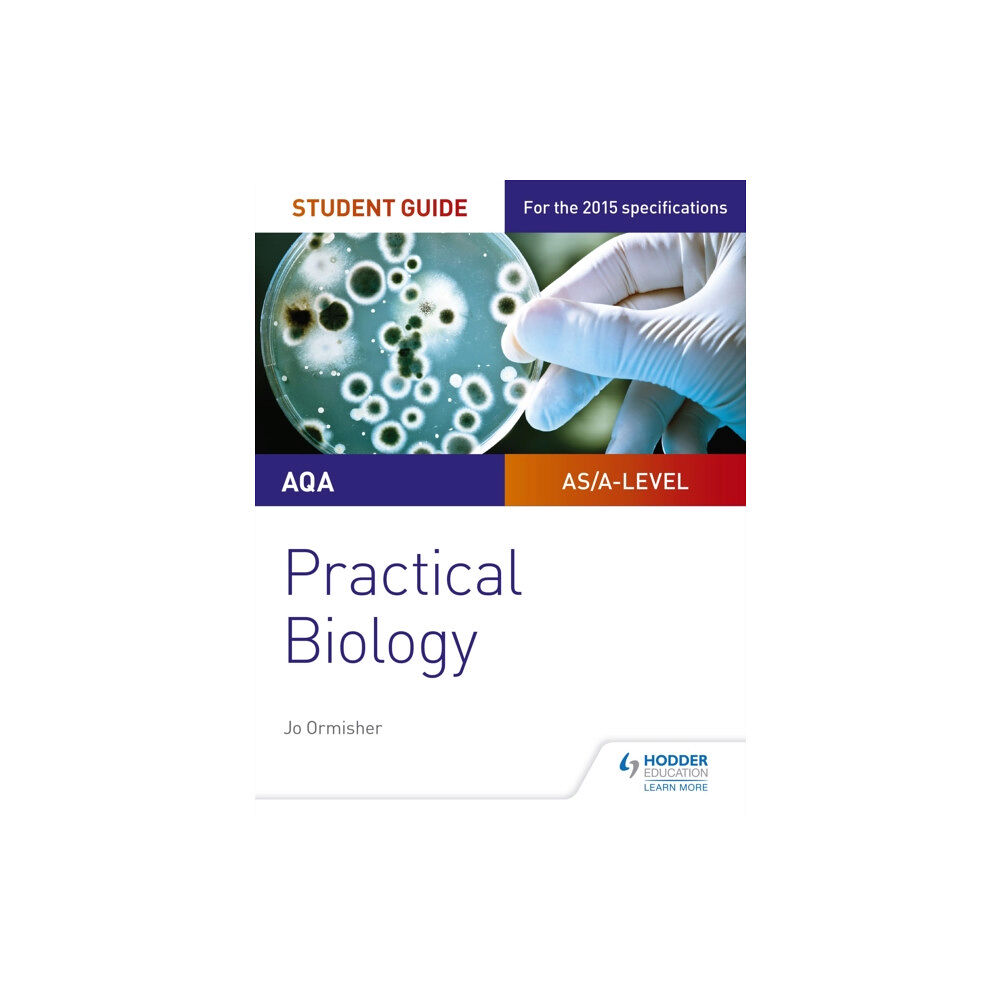
Hachette Learning AQA A-level Biology Student Guide: Practical Biology (häftad, eng)

- Hem
- Böcker
- Kurslitteratur
- Matematik & Naturvetenskap
- AQA A-level Biology Student Guide: Practical Biology (häftad, eng)
AQA A-level Biology Student Guide: Practical Biology (häftad, eng)
Exam Board: AQA
Level: AS/A-level
Subject: Biology
First Teaching: September 2015
First Exam:...
Produktbeskrivning
Exam Board: AQA
Level: AS/A-level
Subject: Biology
First Teaching: September 2015
First Exam: June 2016
Ensure your students get to grips with the core practicals and develop the skills needed to succeed with an in-depth assessment-driven approach that builds and reinforces understanding; clear summaries of practical work with sample questions and answers help to improve exam technique in order to achieve higher grades.
Written by an experienced teacher, this Student Guide for practical Biology:
- Help students easily identify what they need to know with a concise summary of required practical work examined in the A-level specifications.
- Consolidate understanding of practical work, methodology, mathematical and other skills out of the laboratory with exam tips and knowledge check questions, with answers in the back of the book.
- Provide plenty of opportunities for students to improve exam technique with sample answers, examiners tips and exam-style questions
- Offer support beyond the Student books with coverage of methodologies and generic practical skills not focused on in the textbooks.
| Format | Häftad |
| Omfång | 104 sidor |
| Språk | Engelska |
| Förlag | Hachette Learning |
| Utgivningsdatum | 2017-06-30 |
| ISBN | 9781471885587 |
Specifikation
Böcker
- Format Häftad
- Antal sidor 104
- Språk Engelska
- Utgivningsdatum 2017-06-30
- ISBN 9781471885587
- Förlag Hachette Learning
Leverans
Vi levererar ditt paket med Budbee, Instabox och DB Schenker. Frakten kostar 49 kr men handlar du för över 499 kr är det fri frakt. De exakta leveranstiderna för varje produkt ser du direkt på produktsidan och i kassan. När din order skickats får du en spårningslänk via e-post eller SMS.
Betalning
Hos oss betalar du tryggt via Avarda. Du kan välja mellan Swish, kort (VISA/MasterCard), faktura med 30 dagar eller konto för delbetalning. Alla köp sker krypterat och säkert.
Retur & reklamation
Som privatkund har du 14 dagars ångerrätt enligt distansavtalslagen. Retur kostar 49 kr och bokas via kundtjänst innan du skickar tillbaka varan. Återbetalning sker alltid via samma betalmedel du använde vid köpet.
Du har 3 års reklamationsrätt enligt konsumentköplagen. Vid godkänd reklamation står vi för returfrakten. Kontakta oss på [email protected] om du vill göra en retur eller reklamation, så guidar vi dig genom processen.
Specifikation
Det finns tyvärr inga specifikationer att visa för denna produkt.